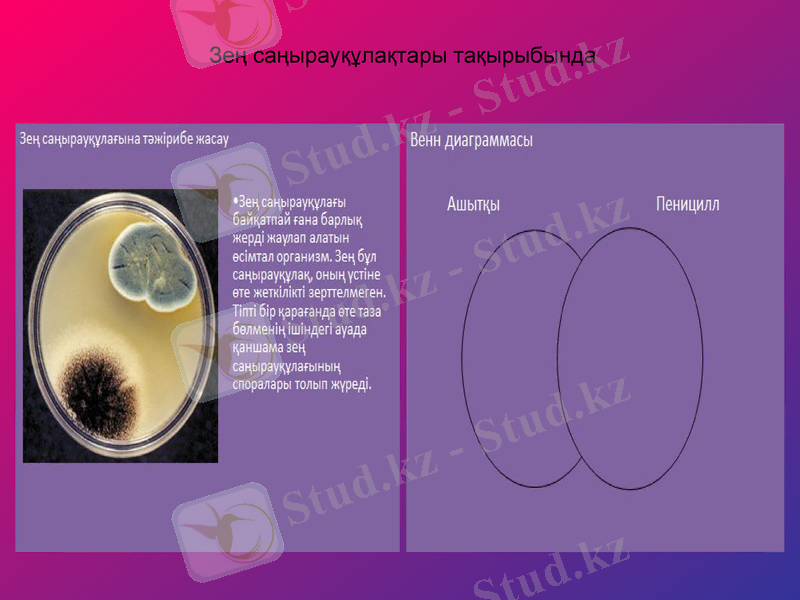
Slide 12

Биология пәнін оқытуда электрондық оқулықтар мен интерактивті ақпараттық-коммуникациялық технологияларды қолданудың тиімділігі



Ақжайық ауданы. Болдырев негізгі мектебінің химия-биология
пәнінің мұғалімі
Кенжеғалиева Нұрзия Аманғалиқызы

Биология сабақтарында
электронды оқулықты қолдану.
Баяндама тақырыбы:

Жалпы білім берудің мақсаты-терең білімнің, кәсіби дағдылардың негізінде еркін бағдарлай білуге, өзін-өзі дамытуға адамгершілік тұрғысынан жауапты шешімдерді қабылдауға қабілетті жеке тұлғаны қалыптастыру, яғни жеке тұлғаны қалыптастыруға негізделген, ақпаратты технологияны терең меңгерген, жылдам өзгеріп жататын бүгінгі заманға лайықты, жаңашыл тұлғаны қалыптастыру.

Қазіргі кезде ақпараттық-коммуникациялық технологияны дамыту білім берудің бір бөлігі. соңғы жылдары ақпараттық-коммуникациялық заман ағымына сай күнделікті сабаққа компьютер, электронды оқулық, интерактивті тақта, қолдану айтарлықтай нәтиже беруде.

Білім берудің кез-келген саласында «Электрондық оқулықтарды» пайдалану оқушылардың танымдық белсенділіктерін арттырып қана қоймай логикалық ойлау жүйесін қалыптасыруға, шығармашылықпен жұмыс жасауына жағдай жасайды. Осы орайда биология пәнін оқытуда қолданылатын жаңа ақпараттық технологияларға интерактивті оқыту құралдарымен электрондық оқу құралдарын жатқызуға болады.

Электрондық оқулықпен оқытудың негізгі мақсаты: оқыту процесін үздіксіз және толық деңгейде бақылау, сонымен қатар ақпараттық ізденіс қабілетін дамыту. Биология пәніне арналған электрондық оқулықтың тест бөлімі арқылы пән курсы бойынша оқушы толық ақпарат алып өз білімін тексере алады.




Электронды оқулық көмегімен зертханалық жұмыстар жүргізу оқушылардың зертханалық құрал-жабдықтарды қолмен ұстап көрмеседе, визуальді түрде сол құрал-жабдықтарды пайдаланып, зертханалық жұмыс жүргізуіне қол жеткізеді.

Орындалатын тапсырмалар:
1. Штативті (тұтқалы) ұлғайтқыш қол әйнек пен микроскоптың құрылысын салыстырып қарап, айырмашылығын анықтап, жаз. Микроскоптың бөліктерінің орналасуымен танысып, қалай аталатынын жаз. Ұлғайтқыш құралдардың қанша есе үлкейтіп көрсететінін анықта.
2. Микроскопқа керекті құрал-жабдықтармен танысып, қалай пайдалану керектігіне зер сал.
Зең саңырауқұлақтары тақырыбында



Балықтың ішкі құрылысын зерттеңіз

Сурет бойынша өтірік өлең құрастыру
Құмырсқа мен арыстан,
Жер бетінде алысқан.
Тасбақа мен қарлығаш,
Көк жүзінде жарысқан.
Саухан Тұрар 6 класс

Гүл неге жылайды?
Эссе
Суық, солу, жұлу, таптау, байқамау, талғамай бере салу, тікен қаулап өсіп кету, күн көзінен таса қалу, сусау /шөлдеу/

Қабылдау мен
есте сақтау
жоғары деңгейде
болады
Пән бойынша
базалық білімді
меңгеру
Алған білімді
жүйелеуге
мүмкіндік береді
Уақытты
үнемдеу
Көрнекілікті
қолдану
деңгейі тиімді
Күтілетін
нәтиже

Қазіргі уақытта биология пәндерінен электрондық оқулықтардың тиімді әдістерін таңдап алып, практикалық сабақтарда оны көрсете білу мұғалімнің жеке тәжірбиесіне, шығармашылық ізденісіне байланысты.
Бұл сабақты түрлендіруге дәстүрлі оқыту әдістеріне жаңа элементтер енгізуге мүмкіндік жасайды, оқушылардың пәнге қызығушылығын арттырып, оқу сапасын көтереді.

“Жақсы дерлік те, жаман дерлік те бір әдіс жоқ, олардың белгісі -бір ғана әдісті болу, шеберліктің белгісі-түрлі әдісті болу. Мұғалім әдісті көп білуге тырысу керек, оларды өзіне сүйеніш, қолқабыс нәрсе есебінде қолдану керек”. А. Байтұрсыновді.

Назарларыңызға рахмет!
- Іс жүргізу
- Автоматтандыру, Техника
- Алғашқы әскери дайындық
- Астрономия
- Ауыл шаруашылығы
- Банк ісі
- Бизнесті бағалау
- Биология
- Бухгалтерлік іс
- Валеология
- Ветеринария
- География
- Геология, Геофизика, Геодезия
- Дін
- Ет, сүт, шарап өнімдері
- Жалпы тарих
- Жер кадастрі, Жылжымайтын мүлік
- Журналистика
- Информатика
- Кеден ісі
- Маркетинг
- Математика, Геометрия
- Медицина
- Мемлекеттік басқару
- Менеджмент
- Мұнай, Газ
- Мұрағат ісі
- Мәдениеттану
- ОБЖ (Основы безопасности жизнедеятельности)
- Педагогика
- Полиграфия
- Психология
- Салық
- Саясаттану
- Сақтандыру
- Сертификаттау, стандарттау
- Социология, Демография
- Спорт
- Статистика
- Тілтану, Филология
- Тарихи тұлғалар
- Тау-кен ісі
- Транспорт
- Туризм
- Физика
- Философия
- Халықаралық қатынастар
- Химия
- Экология, Қоршаған ортаны қорғау
- Экономика
- Экономикалық география
- Электротехника
- Қазақстан тарихы
- Қаржы
- Құрылыс
- Құқық, Криминалистика
- Әдебиет
- Өнер, музыка
- Өнеркәсіп, Өндіріс
Қазақ тілінде жазылған рефераттар, курстық жұмыстар, дипломдық жұмыстар бойынша біздің қор #1 болып табылады.



Ақпарат
Қосымша
Email: info@stud.kz